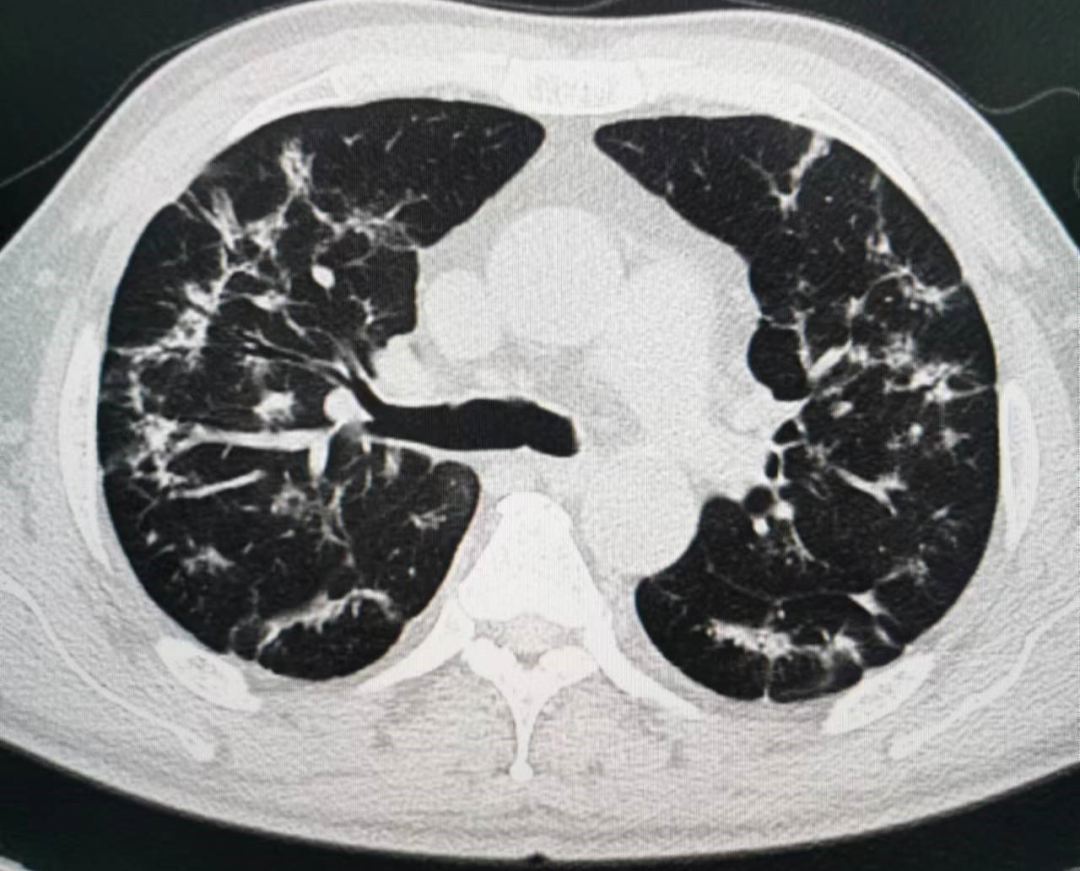

随着感染新冠病毒的人越来越多,做CT检查的病人呈井喷式增长。放射科CT室成为了各医院最忙碌的明星科室。那么新冠病毒所致的肺炎在CT片上到底长什么样?现在让我们一起揭开它的神秘面纱。
新型冠状病毒(COVID-19)为β属冠状病毒,其所致肺炎在CT表现上除与其他病毒引起肺炎的相似之处外,也有其独特之处。
我们从以下几方面了解一下
一、病灶分布特点
1.病灶以肺外围宽基底分布,背侧为主,以两肺下叶为著,与胸膜常紧贴。

病理学基础:提示病变多首先侵犯皮层肺组织的细支气管及肺泡上皮。
2.病灶沿着胸膜下呈长条片状分布,长轴与胸膜平行,一般不引起胸膜反应。

病理学基础:提示病变首先累及皮层肺组织,不按肺段解剖分布。
3.病灶沿支气管血管束分布较多病灶常沿着支气管血管束分布,从外周向中央进展。
病理学基础:提示病灶常沿着间质分布蔓延。
二、病灶形态特点
(一)直接形态特点表现
1.多叶多灶分布,病灶可同时散在于不同的肺叶、肺段。

2.单叶片状病灶,部分病人病灶局限于单叶成片状磨玻璃影分布。

3.孤立性结节样病灶,部分病灶成孤立结节样分布。

4.结节伴晕征,部分实性结节病灶周围出现磨玻璃密度影,边缘模糊,称为晕征。

病理学基础:提示病灶中心实变影为肺泡腔内聚集大量富细胞渗出液,显示为实性密度灶;其周围肺泡亦见渗出,包含炎症细胞、蛋白质、纤维素等,形成“膜状物”,或形成磨玻璃密度阴影。
5.细网格征铺路石征:在磨玻璃病灶内部常可见细网格状阴影,类似铺路石状,称为细网格征或铺路石征。

病理性基础:提示为小叶间隔及小叶内间隔增厚,反映间质性病变或血管网增多,符合肺部病毒感染病理特性。
(二)间接形态表现特点
1.空气支气管征:实变肺组织内可见含气支气管正常穿行,未见明显狭窄和扭曲,少部分病例可以看到支气管壁增厚、管腔通畅,而晚期病变可以出现支气管牵拉、扭曲征象。

2.血管增粗征:在亚实性病灶内部清晰显示血管走行,部分血管管径增粗,甚至比近端更粗。

病理学基础:提示血管周围间质水肿,并非血管内径增粗。
三、病灶密度绝大多数案例出现磨玻璃病灶,最低测得 CT 值约为-600Hu ;部分案例磨玻璃病灶与实性病灶共存。

病理学基础:提示此为肺泡间隔毛细血管扩张充血、肺泡腔内液体渗出和小叶间隔间质水肿。
四、少见征象:部分病例可见双侧胸腔积液;纵隔增大淋巴结肿大及心包积液。

五、进展期征象:大多数病例进展迅速,复查 CT 影像发生明显变化。表现为病灶数目明显增多,范围明显扩大,密度增高,病灶分布由外周向中央推进。

病理学基础:提示为肺泡腔内聚集大量细胞渗出液、间质内血管扩张渗出;肺泡连通起来形成融合态势。
六、重症期征象:肺部病变一般在发病后14天左右达到高峰,少部分病例急剧进展,病变累及双侧全肺,呈“大白肺”(肺部受累面积超过70%)其内可见空气支气管征,双侧胸腔可有少量胸腔积液,临床纳入危重症管理。

病理学基础:提示肺泡腔有大量纤维素性渗出。
七、消散期征象:多数病例在14天后进入病灶消散期,表现为病灶逐步吸收,可遗留少许条索状高密度影。少部分病例病程较短,影像可由早期表现直接进入消散期。

病理学基础:提示部分病灶纤维化